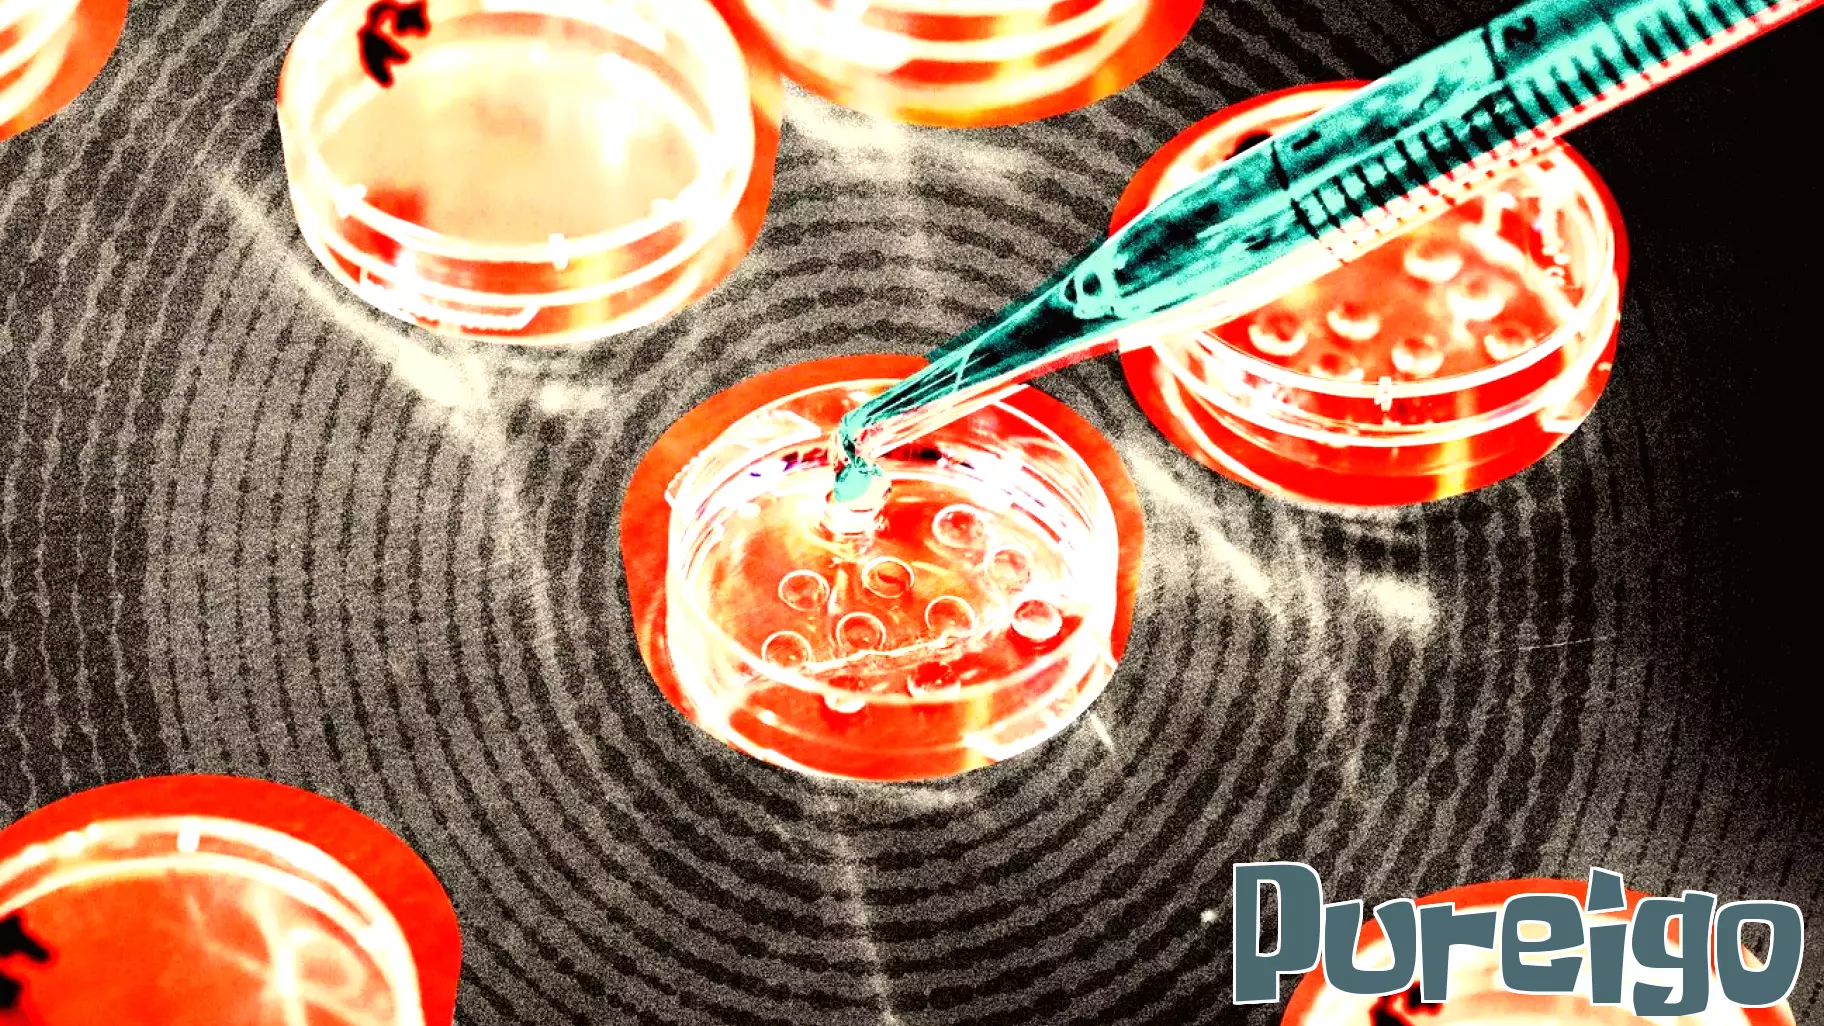
Growing Popularity of Elective IVF Raises Concerns Among Doctors

November 23, 2025 - 04:30
Elective in vitro fertilization (IVF) is becoming increasingly popular as more individuals and couples seek ways to enhance their chances of having healthy children. However, this trend has sparked significant concerns among medical professionals regarding the reliability of embryo screening technologies. Companies promoting these services often tout the concept of "generational health," claiming they can identify embryos free from various complex genetic conditions.
Despite these promises, many doctors argue that the science underpinning embryo scoring is not as robust as advertised. Critics point to the limited understanding of genetic interactions and the potential for false positives or negatives in screening results. This uncertainty raises ethical questions about the implications of selecting embryos based on genetic profiles, as it may lead to societal pressures surrounding genetic "perfection."
As elective IVF continues to gain traction, the medical community is calling for more rigorous research and transparency in the embryo selection process to ensure that prospective parents are fully informed about the risks and limitations involved.
November 22, 2025 - 12:25
Repeat Offender with Troubling History Accepts Plea Bargain Amid Mental Health ConcernsAbdinjib Ibraham has spent the majority of the last decade either incarcerated or receiving treatment at Western State Hospital. His extensive history of violent offenses has raised significant...
November 21, 2025 - 21:37
Spice Up Your Life: A Common Ingredient Linked to Enhanced Happiness and Sexual HealthRecent research has highlighted the potential benefits of a common spice in boosting both happiness and sexual health. This spice, often found in kitchens around the world, has been shown to...
November 21, 2025 - 00:49
CDC Revises Stance on Vaccine-Autism Link, Sparking ControversyA recent update on a Centers for Disease Control and Prevention (CDC) webpage has raised eyebrows by altering the long-standing assertion that `Vaccines do not cause autism.` This change appears to...
November 20, 2025 - 07:50
Operation Dudula Disrupts Access to Health Clinics for Foreigners in South AfricaAn anti-migrant group known as Operation Dudula is actively blocking foreigners from accessing public health clinics in South Africa. The group`s actions have raised significant concerns among...